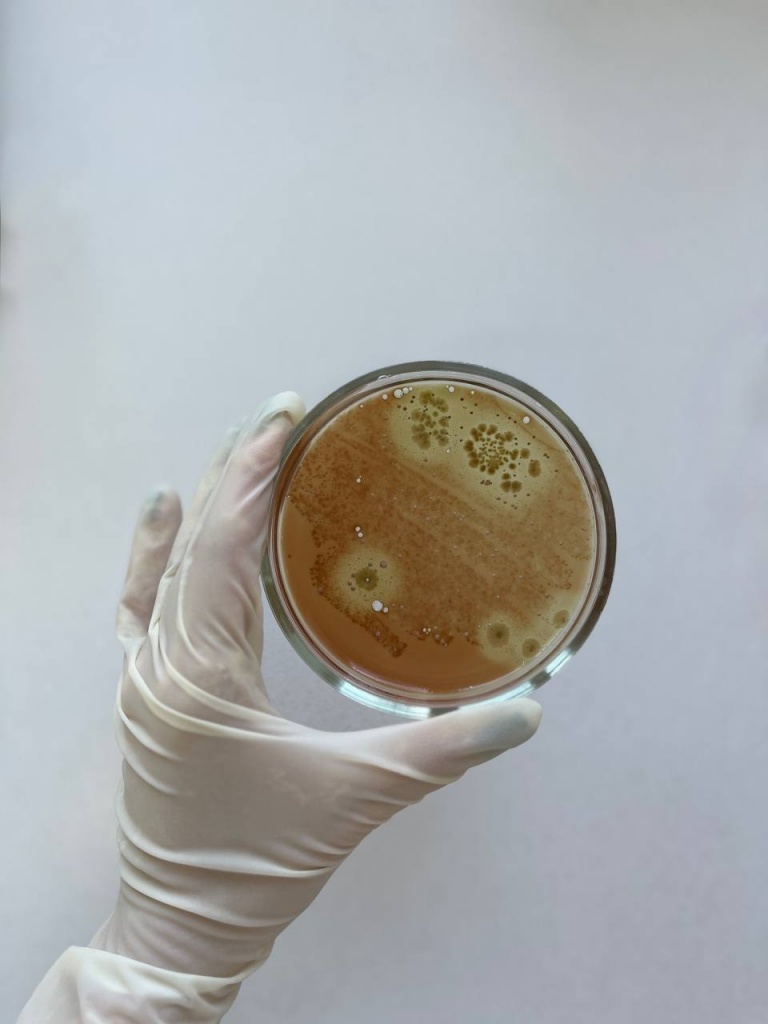
photo_2024-10-31_10-34-46.jpg photo_2024-10-31_10-34-46.jpg
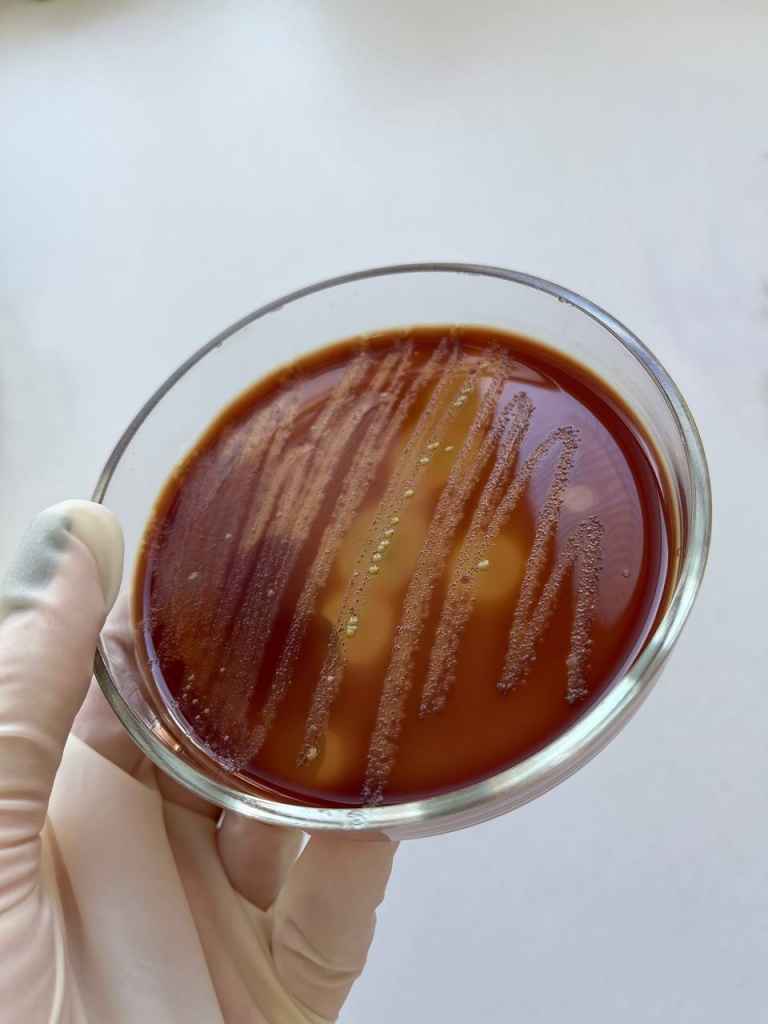
photo_2024-10-31_10-29-20.jpg photo_2024-10-31_10-29-20.jpg

В Вороновском районе зафиксирован рост заболеваемости пневмонией

В сентябре-октябре текущего года в Вороновском районе зарегистрировано 182 случая заболевания пневмонией, из них 122 — у детей. Наименьший возраст заболевшего пневмонией ребенка — 4 месяца. Немало случаев заболевания и в пожилом возрасте, самому возрастному пациенту — 88 лет.
Пневмония относится к неблагоприятным осложнениям острых респираторных инфекций. Осенний рост заболеваемости ОРИ обусловлен тем, что люди не учитывают изменение погодных условий: по привычке одеваются недостаточно тепло и из-за переохлаждения становятся более восприимчивы к простудным заболеваниям. Влияние оказывает и возвращение после летнего отдыха в так называемые замкнутые коллективы: учреждения образования, на работу. В такой обстановке инфекция передается намного быстрее.
Пневмония — это острое инфекционно-воспалительное заболевание легких, вызванное бактериями, вирусами, простейшими или спорами грибов. Сотрудники лабораторного отдела Вороновского районного ЦГЭ проводят исследования мокроты, промывных вод бронхов с последующей идентификацией выделяемых культур и определением их чувствительности к лекарственным средствам. Бактериальными возбудителями пневмонии по этиологической структуре являются Streptococcus spp., Staphylococcus aureus, Streptococcus pneumoniae, Klebsiella pneumoniae.

Следует знать, что при лечении заболеваний, возбудителями которых являются бактерии, используются назначенные врачом антибиотики, а лечение вирусных заболеваний можно предупредить вакцинопрофилактикой.
Вот несколько простых, но очень важных советов, которые помогут защитить организм:
o соблюдайте гигиену. Мойте руки с мылом или обрабатывайте их антисептиком после улицы, перед едой и после туалета;
o не забывайте о проветривании и влажной уборке помещений;
o соблюдайте социальную дистанцию. Старайтесь избегать массовых мероприятий;
o если вы здоровы, то больше гуляйте на улице. Ежедневное пребывание на свежем воздухе уменьшает восприимчивость к инфекциям;
o одевайтесь по погоде;
o подумайте о сбалансированном рационе. Питаться нужно полноценно и разнообразно, в рационе обязательно должны присутствовать овощи, фрукты, ягоды;
o не занимайтесь самолечением и своевременно обращайтесь к врачу;
o обязательно сделайте прививку против гриппа.
Алеся БЕРЦЕВИЧ, помощник врача-эпидемиолога Вороновского районного ЦГЭ.
